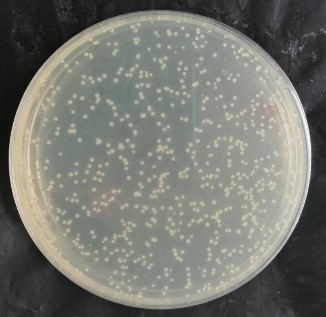

一、扩增流程
收到产品后,请先根据产品管壁标签来判断产品形式,并在扩增前准确查找该质粒菌株的抗性、感受态和培养温度。
1、质粒干粉(常温运输,存于-20度,90天保质期,请务必转化挑单克隆培养,不要直接使用和测序)
①收到质粒干粉后请先5000rpm离心1min,再加入20μl ddH2O去离子水溶解质粒;
②取1支100μl 感受态于冰上解冻10min,加入2μl质粒,再冰浴30min后,42℃热激60s,不要搅动,再冰浴2min;(从第二步开始均要在超净工作台中无菌操作)
③加入900μl无抗的LB液体培养基,180rpm震荡37℃培养45min;
④6000rpm离心5min,仅留100μl上清液重悬细菌沉淀,并涂布至目标质粒抗性的LB平板上;(可使用本平台的平板涂布专用玻璃珠进行涂布,可以比传统涂布方法获得更多转化子)
⑤将平板正向培养1h,再倒置37℃培养14h。如果要求是30度则培养20h;
(菌落过多则将质粒稀释后再转化。没有菌落则加入10μl质粒转化。另不要直接转表达感受态,要先转克隆感受态,重提质粒后再导入表达感受态)
⑥挑取单菌落至LB液体培养基中,加入对应抗生素,220rpm震荡培养14h,根据实验需要和质粒提取试剂盒说明书提取质粒。
2、甘油菌种(冰袋运输,存于-80℃,保质期90天,请务必划线挑单克隆培养)
四区划线后挑单菌落培养,酵母菌需要先液体复苏再四区划线,再挑单菌落液体培养。
3、穿刺菌种(冰袋运输,存于4℃,保质期7天)
穿刺接种,液体培养后四区划线,再挑单菌落液体培养。
4、菌落平板(冰袋运输,存于4℃,保质期7天)
直接挑取单菌落至液体培养基中。
5、液体质粒(冰袋运输,存于-20℃,保质期90天)
单独提取的液体质粒收到后可直接使用。
6、滤纸质粒(常温运输,存于-20度,90天保质期,请务必转化挑单克隆培养,不要直接使用和测序)
收到货后将滤纸画圈部分剪下放入EP管中,加100ul无菌水将滤纸浸湿并浸泡5min,吸取5ul质粒转化,离心全涂。
二、转化图片